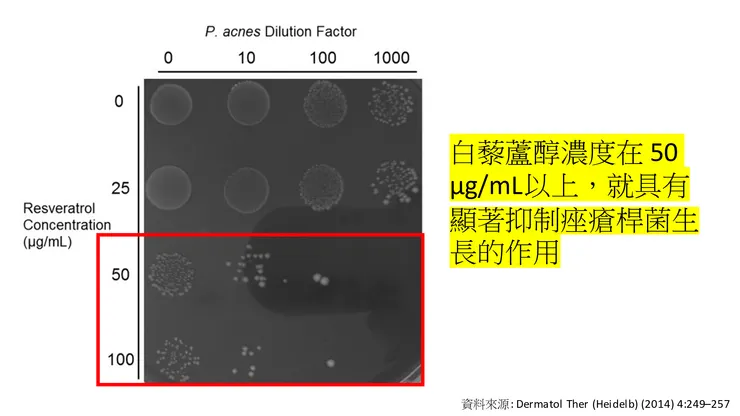
vocus｜新世代的創作平台

《「謝銘峻 醫師 2023.1.10」》
# 痘痘生成的四大機轉
人體痘痘生成主要涉及四個生理機轉:
- 賀爾蒙觸發 – 最主要是雄性激素,促進皮脂分泌(出油增加)
- 痤瘡桿菌 – 主要位於毛囊開口處的痤瘡桿菌增生
- 毛囊皮脂腺管阻塞 – 其中角質形成細胞的過度增生造成老廢角質代謝增加,進而阻塞毛囊皮脂腺管
- 免疫活化,發炎反應增加 – 造成更嚴重的發炎性痘痘


# 白藜蘆醇的抗痘作用

根據2014年,美國研究團隊的報告,濃度在 50 μg/mL以上的白藜蘆醇就具有抑制痤瘡桿菌增生的作用。濃度 100 μg/mL時,抑制作用更好。
延伸閱讀:長痘痘怎麼辦?臉上痘痘一直好不了!5招成功去除臉上「長痘痘位置」

如果跟抗痘藥劑過氧化苯醯(Benzoyl peroxide)來做比較,白藜蘆醇的立即性抗痤瘡桿菌效力沒有過氧化苯醯強(立即性殺菌力),但是對痤瘡桿菌的持續作用效果,白藜蘆醇卻是遠優於過氧化苯醯。

體外細胞毒害性研究顯示,過氧化苯醯(Benzoyl peroxide)對人體細胞的毒害性卻是遠大於白藜蘆醇,這也就是過氧化苯醯(Benzoyl peroxide)只能作為藥劑的原因。
# 白藜蘆醇的痘痘臨床治療



義大利研究團隊利用白藜蘆醇凝膠來治療痘痘的臨床研究顯示:
(1) 痘痘病變: 治療組(添加白藜蘆醇)的平均減少率為53.75%,對照組(未添加白藜蘆醇)的平均減少率為6.1%
(2) 細微粉刺病變: 治療組(添加白藜蘆醇)的平均減少率為66.7%,對照組(未添加白藜蘆醇)的平均減少率為9.7%


# 白藜蘆醇的抗痘機轉
白藜蘆醇為什麼會有不錯的抗痘效果?其作用機轉為何?

- 白藜蘆醇可以抑制痤瘡桿菌的增生
- 白藜蘆醇可以防止角質形成細胞的過度增生,因此可以減少毛囊皮脂腺的阻塞
- 白藜蘆醇具有強效抗發炎作用,可以防止發炎性痘痘的形成

綜合來說,作為一種天然植萃成分,白藜蘆醇在皮膚科學上有著多種不錯的作用效能,包括可以強化皮膚皮障,改善敏感肌,改善泛紅肌;可以減少水分的經皮流失,提升皮膚保水性;增加膠原蛋白含量,提升皮膚彈性;增加皮膚緊實度,改善皮膚粗糙問題;另外也具有良好的抗痘作用。
文章出處:www.dr-hsieh.com





















